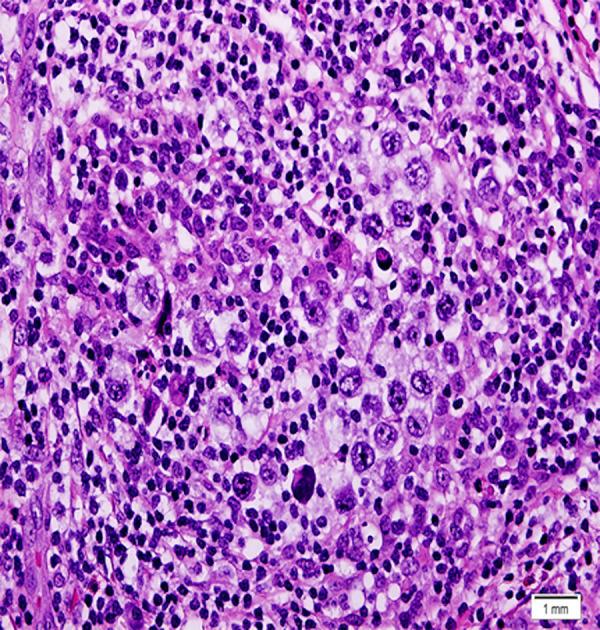

原发性胸腺霍奇金淋巴瘤合并胸腺瘤和重症肌无力:一例报告。
Primary Thymic Hodgkin Lymphoma Coexisting with Thymoma and Myasthenia Gravis: A Case Report.
机构信息
College of Medicine, Imam Abdulrahman Bin Faisal University, Dammam, Saudi Arabia.
Thoracic Surgery Division, Department of Surgery, College of Medicine, Imam Abdulrahman Bin Faisal University, Dammam, Saudi Arabia.
出版信息
Am J Case Rep. 2023 Nov 25;24:e941792. doi: 10.12659/AJCR.941792.
BACKGROUND Myasthenia gravis is a neuromuscular disorder that is strongly associated with thymoma. Although the presence of myasthenia gravis with other tumors is uncommon, approximately 50% of patients with thymoma have myasthenia gravis. Thymic Hodgkin lymphoma should be considered due to the multiple reported cases of patients with myasthenia gravis and Hodgkin lymphoma. In this report, we present the case of 24-year-old woman with myasthenia gravis who was incidentally found to have coexisting thymoma with thymic Hodgkin lymphoma. CASE REPORT A 24-year-old woman with a known case of vitiligo presented with a 2-year history of diplopia and incidental anterior mediastinal mass. Following investigations, myasthenia gravis was diagnosed and managed by pyridostigmine, prednisolone, and azathioprine. Regarding the anterior mediastinal mass, thymoma was suspected based on the presence of myasthenia gravis and radiological findings. She underwent extended transsternal thymectomy. The final histopathological report of the dissected thymus disclosed Hodgkin lymphoma pathology coexisting with thymoma. After the diagnosis of Hodgkin lymphoma nodular sclerosis type IIA was confirmed, 6 cycles of chemotherapy were administered. Four years of follow-up revealed no evidence of Hodgkin lymphoma. However, her symptoms of myasthenia gravis persisted despite Hodgkin lymphoma remission. CONCLUSIONS There is an unclear association between myasthenia gravies and Hodgkin lymphoma. Prior reports revealed regression of myasthenia gravies following Hodgkin lymphoma management, which suggests that myasthenia could be a complication of Hodgkin lymphoma. However, in our case, myasthenia gravis persisted after Hodgkin lymphoma management; therefore, further studies are needed to explore this association.
背景
重症肌无力是一种与胸腺瘤密切相关的神经肌肉疾病。虽然其他肿瘤合并重症肌无力并不常见,但约 50%的胸腺瘤患者合并有重症肌无力。由于有报道称重症肌无力和霍奇金淋巴瘤的患者存在多种情况,因此应考虑胸腺霍奇金淋巴瘤的可能性。在本报告中,我们介绍了一例 24 岁女性重症肌无力患者,该患者偶然发现合并胸腺瘤和胸腺霍奇金淋巴瘤。
病例报告
一名 24 岁女性,患有白癜风,出现复视 2 年,偶然发现前纵隔肿块。经过检查,诊断为重症肌无力,采用吡啶斯的明、泼尼松龙和硫唑嘌呤进行治疗。鉴于前纵隔肿块,考虑到重症肌无力和影像学发现,怀疑为胸腺瘤。她接受了广泛的胸骨切开胸腺切除术。解剖胸腺的最终组织病理学报告显示霍奇金淋巴瘤与胸腺瘤并存。在诊断为霍奇金淋巴瘤结节性硬化型 IIA 后,给予 6 个周期的化疗。4 年的随访未发现霍奇金淋巴瘤的迹象。然而,尽管霍奇金淋巴瘤缓解,她的重症肌无力症状仍持续存在。
结论
重症肌无力和霍奇金淋巴瘤之间的关联尚不清楚。先前的报告显示霍奇金淋巴瘤治疗后重症肌无力缓解,这表明重症肌无力可能是霍奇金淋巴瘤的并发症。然而,在我们的病例中,霍奇金淋巴瘤治疗后重症肌无力仍持续存在;因此,需要进一步研究来探讨这种关联。